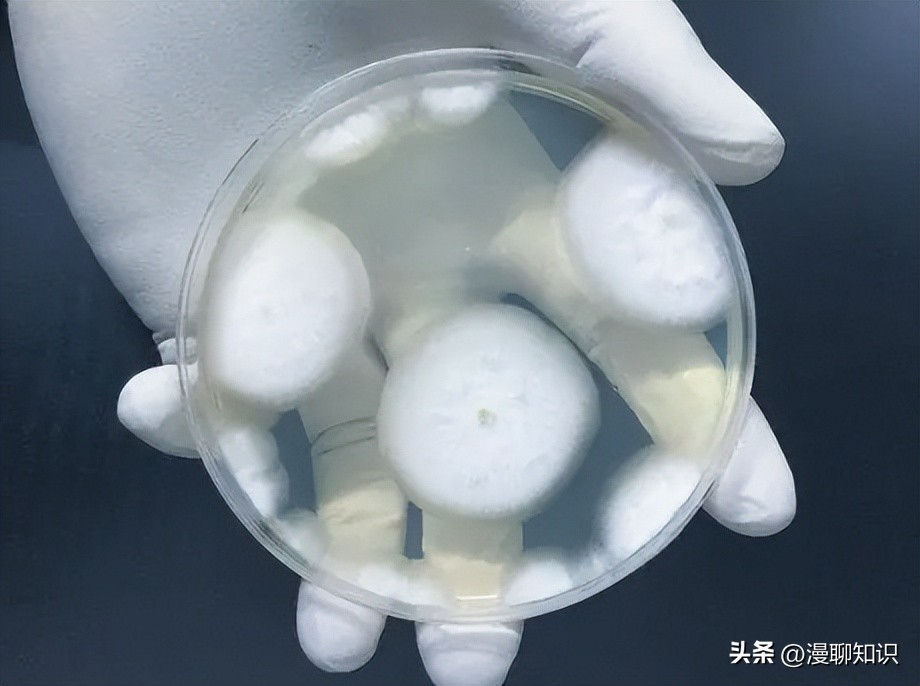
为什么乳酸菌能抑制其他细菌合成,群体感应抑制

阅读文章前,辛苦您点下右上角的“关注”,方便您讨论分享,持续关注每日优质内容~
群体感应调控乳酸菌共培养产细菌素的机制
三组分调控系统介导的群体感应对乳酸菌产细菌素的调控
群体感应又称密度感应,是指微生物以及细胞之间存在的信息交流,细胞之间可以通过逸散的信号分子来感知菌群数量的变化,从而调控一系列相关基因编码蛋白质,履行其相应的生物学功能。
与大部分可进行群体感应的细菌相同,乳酸菌也存在着两套群体感应系统,分别是种内QS系统和种间QS系统。
根据信号分子的种类,可以将QS系统分为AHLs型、自诱导肽(Autoinducing Peptide,AIP)型、共有的LuxS/AI-2型等。
共培养诱导乳酸菌产生细菌素依赖的是寡肽类信号分子AIP介导的三组分调节系统(Three-component regulating system)的自诱导机制和二类信号分子(Type II autoinducer,AI-2)介导的LuxS/AI-2群体感应诱导机制。

三组分调控系统在诱导乳酸菌细菌素合成方面起核心作用,其通常由一个双组分系统(Two-component system,TCS)和一个信号分子组成,这个信号分子就是细菌自身生成并释放到外界的自诱导物(Autoinducer,AI)或自诱导肽,而TCS则由组氨酸激酶(Histidine protein kinase,HPK)和反应调节蛋白(Response Regulator,RR)组成。
AI或AIP会随着两种细菌密度增加而增加,达到阈值时就会刺激细菌内特定基因表达,共培养的细菌通过这个过程就可以完成单个细菌无法完成的产细菌素的生理功能。
属于Ⅰ类细菌素的乳酸菌细菌素Nisin的产生过程受到了三组分调控系统的促进,Nisin的三组分调控系统为NICE(Nisin controlled expression)系统。

在该系统中,NICE系统的AIP为Nisin本身,自诱导肽Nisin作为信号分子激活了nis ABTCIPRKFEG的表达,从而促进更多的Nisin产生。
Ⅱ类细菌素与Ⅰ类细菌素之间的三组分调控系统略有异同,一些细菌的三组分调控系统以膜组氨酸蛋白激酶(Member Histidine Protein Kinase,MHK)来替代HPK,其自诱导物一般由特定基因簇调控生成,如片球菌素产生菌。
不同的菌株的自诱导物编码的基因簇不相同,典型的操纵子基因簇为plnABCD。
MALDONADO等对L.plantarum NC8的细菌素PLNC8操纵子下游的8.1 kb DNA区域的分析显示其存在至少4个参与细菌素产生的操纵子。
与此同时,PLNC8的基因簇显示出与植物乳杆菌(Lactobacillus.Plantarum)C11中的植物乳杆菌素基因簇的高度同源性。

在这个过程中还发现了一个涉及群体感应机制的三组分调控操纵子。
虽然L.plantarum NC8和L.plantarum C11的诱导因子和组氨酸激酶基因的同源性很低,但二者的反应调节因子PlnD却具有极高的同源性。
在L.plantarum NC8和L.plantarum C11的细菌素操纵子区域都发现了高度保守的L和R区域,这些区域由plnD和plnC基因簇共同调控,在细菌素的产生过程中起到重要作用。
但是对L.plantarum NC8和L.plantarum C11的操纵子区域的研究发现,调节因子PlnC是L.plantarum C11所独有的,L.plantarum NC8中不存在PlnC。
而调节因子plnD的编码基因在L.plantarum C11中过表达,并对PlnA形成抑制。
并且在L.plantarum NC8的操纵子发现了两个长度分别为1.6 kb和3.5 kb的片段缺失,而这样的操纵子结构差异很有可能导致了L.plantarum NC8的三组分调控系统成为产细菌素的组成部分,从而使得NC8与C11的共培养促进了NC8中细菌素产量的增加和调节操纵子的转录。

这说明乳酸菌细菌素的三组分调控系统具有多样性的特点,具有相似三组分调控系统菌株的存在可以作为一种信号,通过PLNC8IF介导的群体感应机制,调控L.plantarum NC8相关基因的表达,促进L.plantarum NC8中细菌素的产生。
MALDONADO-BARRAGAN等从一名健康女性的阴道中分离得到的加氏乳杆菌(Lactobacillus.gasseri)EV1461可产生新型细菌素gassericin E(Gas E),当阴道内有害微生物的数量达到某一个阈值时,L.gasseri EV1461就会调节Gas E的产生,用以抑制有害阴道微生物,从而维持阴道的稳定性。
当L.gasseri EV1461被单独培养时,分离得到的上清液中并没有检测到Gas E,在加入少量有害微生物并培养一段时间后,上清液中明显显示出Gas E活性。
通过对不同处理下的培养物上清液分析检测发现,当L.gasseri EV1461和有害微生物共培养时,上清液中的AIP含量比纯培养L.gasseri EV1461显著增加,AIP含量的增加导致膜相关的HPK磷酸化,从而激活RR,使RR结合到启动子上,激活Gas E基因表达。
L.gasseri EV1461在纯培养条件下所分泌的AIP含量过少,无法支撑群体感应机制调控细菌素Gas E的合成,但在添加外源微生物的条件下,AIP分泌量显著提高,从而激活了Gas E分泌的相关代谢通路。
具有拮抗作用的微生物之间的群体感应也是促进产细菌素微生物提高产量的重要途径,毒力因子可能对群体感应存在间接的促进作用。

二类信号分子介导的群体感应对乳酸菌细菌素的调控
诱导乳酸菌共培养产生细菌素的除了AIP介导的三组分调控机制以外,还有由二类信号分子介导的LuxS/AI-2群体感应系统诱导机制。
AI-2是一种通用的信号分子,用于种间交流。
AI-2首先在哈弧氏菌(Vibrio hashii)被发现,其化学名称为呋喃硼酸二酯(Furanosyl borate diester),AI-2是以S-腺苷甲硫氨酸(S-Adenosylmethionine)为前体物质经过多次酶促反应生成,在AI-2的生成过程中,LuxS蛋白起到了重要的催化作用。
一些研究表明LuxS基因的表达对AI-2的产生起到了重要作用,某些LuxS基因缺失突变株不再显示出AI-2活性。
近几年的研究发现,AI-2在微生物细胞间交流中起到关键作用,并且广泛存在于革兰氏阴性菌和革兰氏阳性菌中。

AI-2能够成为细菌用来感受外界环境中不同种属细菌数量的媒介,从而调节自身的生理变化。
MAN等发现L.plantarum KLDS1.0391与瑞士乳杆菌(Lactobacillus helveticus)KLDS1.9207共培养时,编码PlnD(反应调节子)和PlNC8HK(诱导因子)的基因表达上调,两种基因表达的上调导致细菌素的活性显著增加。
并且AI-2的活性浓度也随着L.plantarum KLDS1.0391数量的增加而增加,二者呈现正相关的趋势,当AI-2达到一定浓度时,会启动三组分调控系统的转录调控周期。
AI-2与HPK结合,复合物在经过硫酸化和去磷酸化等一系列反应之后将AI-2传递给下游的RR,刺激共培养环境,从而启动细菌素的生产和自我诱导相关基因的转录。

通常来说,共培养产细菌素是通过共培养产生菌和其他微生物之间共培养,如直接接触的刺激等,很少看到自诱导因子在细胞外空间的输出。
本课题组通过对Paracin1.7的研究发现,当枯草芽孢杆菌(Bacillus subtilis)与L.paracasei HD1-7共培养时,L.paracasei能够产生更多的Paracin1.7。
对枯草芽孢杆菌的上清液进行纯化分析后发现数种大小不一的多肽,由此可推断枯草芽孢杆菌上清液中存在着信号分子,使得LuxS/AI-2群体感应系统诱导L.paracasei产生了更多的Paracin1.7。
同时,对L.paracasei HD1-7进行密度依赖实验后发现Paracin1.7对细胞密度有一定的依赖性,且Paracin1.7也具有信号分子的功能,可以诱导群体感应的发生。

这一结果表明自诱导因子可能在细胞外空间输出,从而引发群体感应行为,但是AI-2是否能够直接在细胞外空间诱导群体感应仍然未知。
以上研究结果表明,诱导乳酸菌共培养产生细菌素的原因可能是乳酸菌分泌的自诱导物,或二类信号分子AI-2的增加引发的群体效应,也可能是利用异种微生物存在的刺激引发群体效应进一步诱导乳酸菌产生更多的细菌素。
由此可知,在乳酸菌相关基因表达以及乳酸菌细菌素合成的过程中,群体感应都存在着不可或缺的重要作用。

作为一种高效安全的天然生物抗菌素,细菌素的生产受到越来越多的关注。
目前已有研究结果表明,乳酸菌和其他菌株共培养能够大幅提升细菌素产量。
通过查阅文献发现,在共培养过程中,乳酸菌群体感应机制中的三组分调控系统和LuxS/AI-2发挥了重要作用,尤其是AI-2在调节中间关系以及调控相关基因从而促进细菌素产生等方面发挥的巨大作用更不可忽视。
因此,对于以后的研究提出了以下两点建议:

(1)作为一种群体回响机制,群体感应在不同条件下的作用方式和作用效率各不相同,应该增加关于共培养菌株之间相互感知和相互作用的方式的研究。
(2)增加AI-2在细菌素合成过程中的输出、接收和转导的相关途径的研究。
综上所述,关于乳酸菌共培养机制以及乳酸菌群体感应和AI-2相关作用机制,还需进一步研究探索,为进一步提高乳酸菌细菌素产量以及发现新的细菌素种类提供理论基础,使乳酸菌细菌素在食品工业方面的应用拥有更加广阔的前景。
ATIEH D, AREZOO A, MARZIEH M A, et al. Bacteriocins:Properties and potential use as antimicrobials[J].Journal of clinical laboratory analysis, 2021,36(1):e24093.
PANAGIOTIS C, TINA M. Co-culture-inducible bacteriocin production in lactic acid bacteria[J].Applied microbiology and biotechnology, 2016, 100(10):4297-4308.